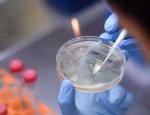

Ugen set i bakspejlet
Skrevet af Torben Wilkenschildt, lør, 26/06/2021 - 07:00
Kanaler
UGEN DER GIK: I denne artikel får du overblikket over ugens nyheder, en kort beskrivelse, link til hver enkelt og til Lørdagsklummen.
| Morgendagens Spanien
KLUMME: Midt i glæden over den nye frihed til at rejse, tynges man godt nok af nogle sorte skyer. |
Fri for maske i det fri!
19/06/2021
![]() | CORONA: God nyhed i sommerheden! Smittetallene er nu så gode og vaccinekampagnen så velsmurt, at vi nu endelig slipper for at skulle bære maske udendørs. Næsten altså... |
21/06/2021
![]() | CORONA: Vi indfører også de nye farver i denne statistik, da vi fra på lørdag ikke skal tale om andre... |
21/06/2021
![]() | PENGE & FORBRUG: Lejepriserne på biler er skudt i himlen denne sommer af den simple årsag, at der mangler biler. |
21/06/2021
![]() | CORONA & REJSE: Uanset hvad der lokker, har europæerne fået nok af “staycation”. Knap tre ud af fire rejser til udlandet denne sommer. |
21/06/2021
![]() | CORONA: Alicante, El Campello og Benidorm - ja hele Valencia Regionen melder sig også i rækken af steder, der lukker strandene til Sct. Hans. Og hvis man ikke retter ind, kan det koste dyrt. |
21/06/2021
![]() | CORONA: Eksperter forventer, at Delta-varianten vil være den dominerende i Spanien om en måned. |
21/06/2021
![]() | ÅRSTID: Sommeren 2021 er begyndt, og det markeres med årets længste dag. Vi ser på, hvilke sange der bare skriger “sommer”... |
22/06/2021
![]() | CORONA: Flere melder sig under tiltaget om at aflyse dette års Sct. Hans-fejring og lukker strandene. |
22/06/2021
![]() | POLITIK: Pedro Sánchez meddelte i går, at Ministerrådet i dag vil benåde de politiske fanger i Catalonien. |
22/06/2021
![]() | PENGE & FORBRUG: Regeringen godkender torsdag en midlertidig sænkning af moms på elektricitet. Der er tale om mere end en halvering, men det er ikke alle, der får glæde at det. |
22/06/2021
![]() | FLY & REJSE: Både Vueling og EasyJet har øjnet muligheden for at få fingre i de Spaniens-lystne danskere. |
22/06/2021
![]() | VIDEO: Kvinde lovede kæresten en overraskelse, men efterlod ham på en støvet vej. Han havde nemlig smidt hendes hund ud, fordi den ikke var raceren. Nu kan du prøve at føle det samme som ham, sagde hun og trykkede speederen i bund. |
23/06/2021
![]() | FLY & REJSER: Antallet af internationale flypassagerer eksploderer med 71 procent på en enkelt måned. |
23/06/2021
![]() | CORONA: Restriktioner forlænges, droppes og lempes, så du du egentlig styr på reglerne for barer, restauranter og natklubber i de forskellige spanske regioner lige nu? |
23/06/2021
![]() | VIDEO: Renfe lancerer sit lavpristog mellem Madrid og Barcelona med billetter fra syv euro. Og i morges kørte de første tog af sted. |
23/06/2021
![]() | CORONA: Hver region har sine egne procedurer for, hvordan man får fingre i det fælles EU-coronapas, der sikrer testfri rejse i EU. Fra i dag er Kanarieøerne også kommet på banen. |
24/06/2021
![]() | SAMFUND: Der skal være styr på det hele i Alicante, når der kommer strandgæster denne sommer. |
24/06/2021
![]() | POLITIK: Måling viser, at et flertal blandt befolkningen mener, at Sánchez kun har taget initiativ til benådningerne for at redde sit eget skind. |
24/06/2021
![]() | TURISME: Data fra maj viser, at der er grund til optimisme, men nordiske turister tegner sig fortsat for en forsvindende lille andel. |
24/06/2021
![]() | CORONA: I går besluttede ministerrådet nye regler for maskebrug i det fri, og i dag skriver man under. Dermed slutter et års maskebal, men kun delvist. |
24/06/2021
![]() | CORONA: Ny undersøgelse sætter tal på effektiviteten af vaccinerne på plejehjem i Spanien, og det ser mildest talt positivt ud. |
25/06/2021
![]() | CARMENS KØKKEN: Kær tun har mange navne, og dagens opskrift kommer hurtigt an på, hvor du bor. Men uanset geografi bliver retten lige lækker. |
25/06/2021
![]() | CORONA: Ikke siden den spanske syge har så mange mennesker mistet livet på et år. |
25/06/2021
![]() | CORONA: Fra i morgen kan du igen smile til folk på din vej. Når du kan sikre halvanden meter til andre, behøver du nemlig ikke længere maske udendørs. |
25/06/2021
![]() | SAMFUND: Fra i dag kan man i Spanien få hjælp til at afslutte livet på en værdig måde. |
Kan måske også interessere dig
Ugen set i bakspejlet
I denne artikel får du links til alle ugens nyheder.
Udskriver valg i utide - Uligheden vokser eksplosivt i Spanien - Kongeligt forbud mod løbehjul
Kort og godt om lidt af hvert i tekst, billeder og video …
Ávila – en guide til store oplevelser
Den smukke middelalderby, omgivet af imponerende bymure, er en perle med en rig katolsk arv og charmerende gader.
Kommentarer
Der er endnu ingen kommentarer til denne artikel
COPYRIGHT: Det er ikke tilladt at kopiere hverken helt eller delvist fra Spanien i dag uden aftale.
Gratis i din indbakke hver dag!
Abonnér på nyhedsbrevet Spanien i Dag og vær på forkant med begivenhederne.
Klik her for at tilmelde dig.